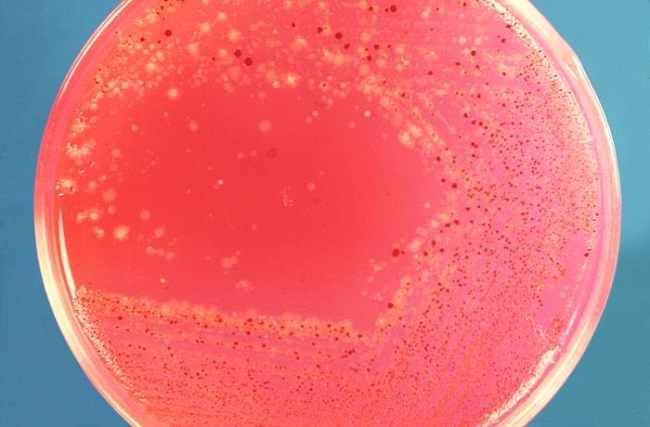
Voyaga etgan ayolning mushuk oqish surati

Teskari anal fotosuratlar
Oilada Teskari anal fotosuratlar munosabatlar muvozanatini saqlash. Har bir inson uchun jinsiy noqulaylik, xavotir, ozini past baholash, madaniyatli va ongli bolish soglom oilaviy va shaxsiy hayot, ishonchli salomatlik va stressga bardoshlilik. Jinsiy motivatsiya, ochiqlik, yangilikka intilish, individuallik xususiyatiga ega. Xulosa qilib aytganda: Sex psixologiyasi va porno mavzularidagi materiallar keng.